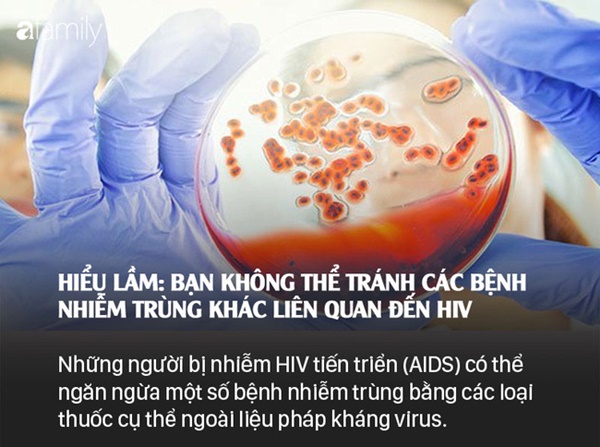
Sống chung với HIV: Những lầm tưởng và sự thật mà bất kì ai cũng nên xem để bảo vệ mình-10

Nhận ra rằng mình phải sống chung với HIV có thể là việc không dễ dàng với bất kì ai bởi rõ ràng có những lầm tưởng hay sự thật về căn bệnh này mà không phải ai cũng nắm rõ.
Cho dù bạn còn trẻ hay là đã có tuổi đời ở bên kia sườn dốc mới phát hiện mình dương tính với HIV thì việc chấp nhận trở thành một thành viên của cộng đồng HIV cũng không phải là việc dễ dàng và nhanh chóng.

Mặc dù HIV được coi là căn bệnh thế kỉ, chưa có thuốc chữa nhưng không có nghĩa là nó quá kinh khủng, người dương tính với HIV (có H.) phải đối mặt với "đường cụt". Điều quan trọng là chúng ta cần hiểu rõ hơn về căn bệnh này, cả những lầm tưởng và sự thật để có thể cùng nhau xây dựng một xã hội tốt đẹp, hướng tới đẩy lùi bệnh và giúp những người có H. biết bảo vệ mình và những người khác, hòa nhập cộng đồng tốt hơn.
Dưới đây là 9 lầm tưởng và sự thật về việc sống chung với HIV mà ai cũng nên nắm được.
1. Nhiễm HIV có nghĩa là bạn bị AIDS
Đây là một lầm tưởng phổ biến.

Virus gây suy giảm miễn dịch ở người (HIV) là một loại virus phá hủy các tế bào miễn dịch CD4 của cơ thể. Những tế bào này vốn có nhiệm vụ chống lại bệnh tật. Với các loại thuốc phù hợp, có những người có thể bị nhiễm HIV trong nhiều năm hoặc nhiều thập kỷ mà không trải qua giai đoạn HIV tiến triển thành AIDS.
AIDS (hội chứng suy giảm miễn dịch mắc phải) được chẩn đoán khi bạn bị nhiễm HIV cũng như một số bệnh nhiễm trùng cơ hội nhất định hoặc khi số lượng tế bào CD4 của bạn giảm xuống dưới 200.
2. Khó lây nhiễm HIV từ những tiếp xúc thông thường
Đây là sự thật.

Bạn không thể nhiễm hoặc làm lây truyền HIV từ việc ôm ai đó, sử dụng chung khăn tắm hoặc dùng chung cốc. Có thể bị nhiễm HIV từ truyền máu nhưng hiếm gặp. Ví dụ, ở Mỹ, nguồn cung cấp máu được kiểm tra rất cẩn thận. Tuy nhiên, bạn có thể mắc bệnh do quan hệ tình dục không an toàn, dùng chung kim tiêm hoặc xăm mình từ các dụng cụ không được vệ sinh.
3. Dương tính với HIV, bạn chỉ sống được vài năm
Đây là một lầm tưởng.

Nhờ các loại thuốc HIV hiện có, sự thật là nhiều người có thể sống hàng chục năm với HIV trong người và có tuổi thọ thông thường hoặc gần như mức thông thường. Bạn có thể giúp ngăn ngừa nguy cơ HIV tiến triển thành AIDS bằng cách đi khám bác sĩ thường xuyên, uống thuốc và làm theo hướng dẫn của bác sĩ.
4. Bạn sẽ biết mình dương tính với HIV dựa trên các triệu chứng
Thêm một lầm tưởng nữa.

Một số người không biểu lộ dấu hiệu nhiễm HIV trong nhiều năm sau khi mắc bệnh. Tuy nhiên, nhiều người có thể có một số triệu chứng trong vòng 10 ngày đến vài tuần sau khi bị nhiễm bệnh.
Những triệu chứng đầu tiên này tương tự cúm hoặc tăng bạch cầu đơn nhân nhiễm khuẩn và có thể bao gồm sốt, sưng hạch bạch huyết, đau họng, phát ban và đau cơ. Chúng thường biến mất sau vài tuần và bạn có thể không biểu hiện triệu chứng nữa trong vài năm. Cách duy nhất để xác định bạn bị nhiễm HIV là đi xét nghiệm.
5. Có thể chữa khỏi HIV
Ở hiện tại, đây là lầm tưởng.

Không có cách chữa trị HIV trong hầu hết các trường hợp, nhưng điều trị có thể kiểm soát lượng virus và giúp duy trì hệ thống miễn dịch của bạn. Một số loại thuốc can thiệp vào protein HIV cần sao chép chính nó; Những loại khác ngăn chặn virus xâm nhập hoặc chèn vật liệu di truyền của nó vào các tế bào miễn dịch của bạn.
Tất cả những người nhiễm HIV nên bắt đầu điều trị. Những loại thuốc này được gọi là liệu pháp kháng virus. Bác sĩ có thể cho bạn biết những sự kết hợp thuốc nào là tốt nhất cho bạn.
6. Bất cứ ai cũng có thể bị dương tính HIV
Đây là sự thật.

Khoảng 37.600 người ở Hoa Kỳ bị nhiễm HIV mỗi năm và hơn 12.000 người bị AIDS thiệt mạng mỗi năm. Bất cứ ai cũng có thể bị nhiễm HIV - đàn ông, phụ nữ, trẻ em và những người đồng tính hoặc dị tính.
Đàn ông quan hệ tình dục với nam giới chiếm khoảng 26.300 trường hợp nhiễm HIV mới được chẩn đoán mỗi năm. Phụ nữ chiếm khoảng 7.400 trường hợp được chẩn đoán mới. Người Mỹ gốc Phi tiếp tục là nhóm người phải chịu đựng gánh nặng HIV nghiêm trọng nhất, so với các chủng tộc và sắc tộc khác.
7. Quan hệ tình dục là an toàn khi cả hai người cùng nhiễm HIV
Đây là một lầm tưởng.

Chỉ vì bạn và bạn tình đều nhiễm HIV, điều đó không có nghĩa là bạn nên quên đi việc bảo đảm an toàn khi quan hệ tình dục. Sử dụng bao cao su hoặc các loại dụng cụ chắn bằng cao su khác có thể giúp bảo vệ bạn khỏi các bệnh lây nhiễm qua đường tình dục cũng như các chủng HIV khác - vốn có thể kháng thuốc chống HIV. Ngay cả khi bạn đang được điều trị và cảm thấy khoẻ, bạn vẫn có thể lây nhiễm bệnh cho người khác.
8. Dù dương tính với HIV, bạn vẫn có thể có một đứa con khỏe mạnh
Đây là sự thật.

Người mẹ bị nhiễm bệnh có thể truyền HIV cho con trong khi mang thai hoặc quá trình sinh nở. Nhưng bạn có thể giảm thiểu rủi ro bằng cách hợp tác với bác sĩ và tiếp nhận sự chăm sóc cũng như thuốc men phù hợp. Phụ nữ mang thai nhiễm HIV có thể dùng thuốc để điều trị nhiễm trùng và giúp bảo vệ em bé khỏi virus.
9. Bạn không thể tránh các bệnh nhiễm trùng khác khi nhiễm HIV
Đây là lầm tưởng.
Những người nhiễm HIV vẫn có thể tránh các bệnh nhiễm trùng như viêm phổi, lao, nhiễm nấm candida, bệnh do virus cytomegalo và bệnh nhiễm ký sinh trùng toxoplasma. Cách tốt nhất để giảm thiểu rủi ro là dùng thuốc điều trị HIV.
Những người bị nhiễm HIV tiến triển (AIDS) có thể ngăn ngừa một số bệnh nhiễm trùng này bằng các loại thuốc cụ thể ngoài liệu pháp kháng virus. Bạn có thể giảm tiếp xúc với một số vi trùng bằng cách tránh thịt chưa nấu chín, dụng cụ để thú cưng xả phân - nước tiểu và nguồn nước ô nhiễm.
Theo Báo Dân Sinh
Link gốc: https://afamily.vn/song-chung-voi-hiv-nhung-lam-tuong-va-su-that-ma-bat-ki-ai-cung-nen-xem-de-bao-ve-minh-20191117194130996.chn?fbclid=IwAR2UcSrrJwSdYXgok-06Lj2WV1ZqxKQ5g0rERB_hG16A6Q1ReiBr9kk-u7E
